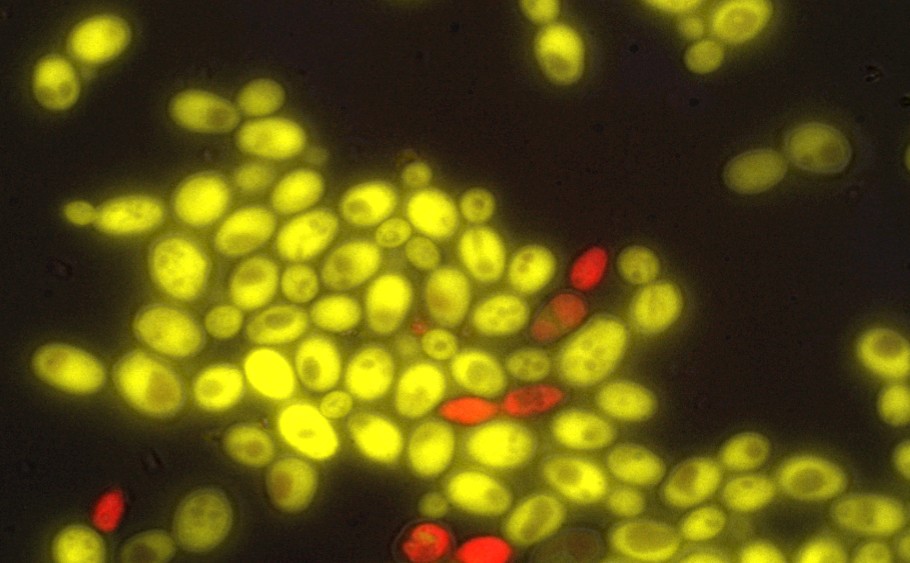

Yeast Cells
Optimal Pitching Rate million/mlPitching yeast at the proper rate significantly reduces the lag time before active fermentation begins, promotes complete fermentation, reduces the risk of infection, and improves the overall quality of your beer Yeast Cells needed billionsNumber of yeast cells needed to achieve optimal pitching rate.

Yeast cells. Asexually by budding which involves a new yeast cell growing out from the original cell to form a new separate yeast organism anerobic respiration Yeast cells can survive with little or no oxygen using it. Yeast cells released from a biofilm have novel properties, including increased virulence and drug tolerance Zap1 Zap1, also known as Csr1 and Sur1 (zincresponsive activator protein), is a transcription factor which is required for the hypha formation in C albicans biofilms Zap1 controls the. Yeast cells an example of a fungus Yeast are singlecelled fungi Like plants, they have a cell wall However, unlike plants, they are unable to make their own food.
Yeast cells are nonmotile and are encased in a cell wall that supports high internal turgor pressure How do we know that yeast is a living organism?. Yeast are microscopic, singlecelled organisms that are classified in the family Fungi Individual yeast cells multiply rapidly by the process of budding, in which a new cell begins as a small bulge along the cell wall of a parent cell In the presence of an abundant food source, huge populations of yeast cells gather. Where oxygen is present, the yeast can concentrate on growing and maintaining its cells, and thus produce little waste (alcohol and carbon dioxide) This process is faster and more efficient.
Yeast consists of single cells They are smaller than animal and plant cells, but slightly larger than bacteria These cells also have several similarities with cells of (green) plants and animals, but lots of differences, which is why they are put into a kingdom of their own. However, the singlechromosome and wildtype yeast cells have nearly identical transcriptome and similar phenome profiles The giant single chromosome can support cell life, although this strain shows reduced growth across environments, competitiveness, gamete production and viability. Yeast cells exhibit a great diversity with respect to cell size, shape, and color Cell size may be 2–3 μm in length up to –50 μm with a diameter of 1–10 μm The yeast cell wall is a rigid structure about 100–0 nm thick and constituting about 25% of the total dry mass of the cell.
Yeast cells are analyzed during the fermentation process Carbohydrates in the wort, which is the water containing sugars from the grains, are converted by the yeast strain into alcohol, carbon dioxide, and numerous byproducts There are several stages in this process, during which the yeast cells are analyzed. This is made more confusing because each yeast strain has different size cells and clumping tendencies We put in a reasonable default of 10 billion cells per gram of dry yeast. Yeast cells released from a biofilm have novel properties, including increased virulence and drug tolerance Zap1 Zap1, also known as Csr1 and Sur1 (zincresponsive activator protein), is a transcription factor which is required for the hypha formation in C albicans biofilms Zap1 controls the.
Cotransform yeast cells (which lack this transcription factor TF) if protein X and “prey” (from library) interact, the 2 domains of yeast TF will be close together (& functional), so activate reporter gene Fig 615 eg if use lacZ reporter gene – blue colour of yeast colony Topic 10 Proteomics Proteomics finding proteins that interact with protein of interest. Yeast cells released from a biofilm have novel properties, including increased virulence and drug tolerance Zap1 Zap1, also known as Csr1 and Sur1 (zincresponsive activator protein), is a transcription factor which is required for the hypha formation in C albicans biofilms Zap1 controls the. One yeast cell can ferment approximately its own weight of glucose per hour In commercial production, selected strains of yeast are fed a solution of molasses, mineral salts, and ammonia When growth ceases, the yeast is separated from the nutrient solution, washed, and packaged Yeast for baking is sold in compressed cakes containing starch or in a dry granular form mixed with cornmeal.
Certain strains may contain up to 500 billion cells per pack while other strains may contain slightly less than 150 billion cells per pack Most importantly, all packs contain the optimal number of viable yeast cells to ferment 5 gallons of wort up to 1060 OG at the time of packaging The number of cells in the pack do not define the success of the brew. It is normal to identify low numbers of yeast cells in stool samples, says a clinical study published in Infectious Disease Reports Some patients exposed to high levels of antibiotics exhibit high levels of yeast in stool samples but this finding does not appear to have any clinical significance High levels of yeast in the stool may be associated with inflammatory conditions, argues Carol A Kumamoto in a review article published in Current Opinion in Microbiology. Baker's Yeast (Saccharomyces cerevisiae) is a single celled fungus used in baking When the fungus is added to dough, it produces carbon dioxide as it consum Baker's Yeast (Saccharomyces.
Yeasts are fungi that grow as single cells, producing daughter cells either by budding (the budding yeasts) or by binary fission (the fission yeasts) They differ from most fungi, which grow as threadlike hyphae. The yeast cells are very polymorphic and are capable of assuming different forms depending upon the medium in which they grow and their age Individually yeast cells are hyaline but in colonies they appear white, creamcoloured or slightly brownish. The yeast cells sprout a hyphal outgrowth, which locally penetrates the mucosal membrane, causing irritation and shedding of the tissues A book from the 1980s listed the pathogenic yeasts of candidiasis in probable descending order of virulence for humans as.
That's not the problem It sounds like you have proctitis, ie inflammation inside the rectum, or per. As yeast replicate by budding off small daughter cells from a larger mother, any population has a large range of cell sizes spread around the median as shown in Figure 2 The haploid strain shown has a median cell volume of 42±2 µm 3 (BNID ) Another common metric is the 25 th 75 th percentile range which here is ≈3060 fL. Cotransform yeast cells (which lack this transcription factor TF) if protein X and “prey” (from library) interact, the 2 domains of yeast TF will be close together (& functional), so activate reporter gene Fig 615 eg if use lacZ reporter gene – blue colour of yeast colony Topic 10 Proteomics Proteomics finding proteins that interact with protein of interest.
Two forms of yeast cells can survive and grow haploid and diploid The haploid cells undergo a simple lifecycle of mitosis and growth, and under conditions of high stress will, in general, die This is the asexual form of the fungus The diploid cells (the preferential 'form' of yeast) similarly undergo a simple lifecycle of mitosis and growth. Learn yeast cells with free interactive flashcards Choose from 103 different sets of yeast cells flashcards on Quizlet. Saccharomyces cerevisiae is a yeast species that is commonly used to make wine, beer, and for baking It can and does infect humans since antibodies against it have been found in 60 to 70% of people with Crohn's disease and 10–15% of patients with ulcerative colitis verses 8% in healthy people.
Froth consisting of yeast cells together with the carbon dioxide they produce in the process of fermentation, present in or added to fruit juices and other substances in the production of alcoholic beverages 3 A powdered or compressed commercial preparation of yeast cells, used chiefly as a leavening agent or as a dietary supplement. Find yeast cells stock images in HD and millions of other royaltyfree stock photos, illustrations and vectors in the collection Thousands of new, highquality pictures added every day. Yeast is a living organism because it "burps",releasing carbon dioxide making it rise.
Bacteria, Fungi, Candida, Yeast cells, or Parasites There are no bacteria, parasites or yeast cells in urine normally If these are present, it can mean you have an infection Presence of yeast in urine to be checked Squamous Cells The presence of squamous cells may mean that the sample is not as pure as it needs to be These cells do not mean there is a medical problem, but your doctor may ask that you give another urine sample. Surprising new mechanism of heat shock response identified in yeast cells by University of Chicago Medical Center After exposure to a heat shock, Sis1 relocates itself within the cell, forming. Yeast, any of about 1,500 species of singlecelled fungi, most of which are in the phylum Ascomycota, only a few being Basidiomycota Yeasts are found worldwide in soils and on plant surfaces and are especially abundant in sugary mediums such as flower nectar and fruits.
Healthy yeast cells can survive many birth scars, so “mother” cells can produce more than one daughter cell, and these daughters in turn produce their own daughter cells Yeast that have weak cell walls from lack of oxygen during their developmental stages cannot survive the necessary repetitive budding that produces a yeast population that is able to ferment the wort cleanly and quickly. Those buds grow so fast that they quickly break off, each becoming a new body And all the. D Allan Drummond, a professor at University of Chicago, prints these scientifically accurate budding yeast cells in brass at 10,000 times their actual size.
Learn yeast cells with free interactive flashcards Choose from 103 different sets of yeast cells flashcards on Quizlet. Dry Yeast billions of cells per gram No one agrees on the number of yeast cells per gram in dry yeast!. Yeast yēst any of various unicellular, nucleated, usually rounded fungi that reproduce by budding;.
“The number of budding yeast cells can tell us a lot of what is happening during fermentation Firstly, during the early stages of fermentation, a high budding percentage is indicative of good start yeast vitality and a healthy fermentation. The stylized yeast cells depicted in several leaves and flower petals are an artist's interpretation of how scientists, using the tools of synthetic biology, genetically engineered yeast to brew. Yeast entering stationary phase adjust their metabolism by altering the transcription of hundreds of genes, leading to many physiological changes, including the accumulation of carbohydrate reserves and the assembly of a more resistant cell wall (reviewed in WernerWasburne et al, 1993).
The bacteria, fungi and yeast that normally inhabit the gastrointestinal tract are called normal flora Pathogenic organisms usually enter the digestive tract via contaminated foods and beverages The most common organisms that cause diarrhea are salmonella, shigella, campylobacter, certain strains of Escherichia coli and Clostridium difficile. This is made more confusing because each yeast strain has different size cells and clumping tendencies We put in a reasonable default of 10 billion cells per gram of dry yeast. Yeast is widely used in the food and beverage industry The baker’s yeast, Saccharomyces cerevisiae, is used for baking and the same yeast and other variants in the brewery and wine industry Saccharomyces cerevisiae cells are round to ovoid and 5–10 µm in diameter It reproduces by a division process known as budding.
Yeast (Saccharomyces cerevisiae) is a fungus belongs to the phylum Ascomycota Yeast is an unicellular eukaryotic, heterotrophic organism without differentiated plant body It is a widely studied model organism for understanding the eukaryotic cell structure and function Sharing is Caring. A typical yeast cell(a typical unicellular ascomycetes fungi) takes approximately 90 minutes to devide from one to two and another 90 minutes for getting two to four and it goes on till the nutrition medium in which it is growing gets completeing ended up fed by the growing yeast community this nutritional medium could be anything like sugar, bread, beverages (alcohol), etc. Some are fermenters of carbohydrates, and a few are pathogenic for humans brewer's yeast Saccharomyces cerevisiae, used in brewing beer, making alcoholic liquors, and baking bread dried yeast dried cells of any suitable strain of Saccharomyces cerevisiae, usually a byproduct of the brewing industry;.
The left telomere of Saccharomyces chromosome VII was often localized near the nuclear periphery, even in cells lacking the silencing proteins Sir3 or Hdf1 This association was lost in late mitotic cells and when transcription was induced through the telomeric tract Although in silencing competent cells there was no correlation between the fraction of cells in which a telomeric gene was. The yeast begin to use their glycogen reserves (energy stores similar to our fat cells) to provide energy so they can synthesize enzymes and a permeable cell membrane Oxygen is a necessary component of these processes The cell membrane controls the passage of nutrients from the wort into the cell and assists in cell wall construction. Optimal Pitching Rate million/mlPitching yeast at the proper rate significantly reduces the lag time before active fermentation begins, promotes complete fermentation, reduces the risk of infection, and improves the overall quality of your beer Yeast Cells needed billionsNumber of yeast cells needed to achieve optimal pitching rate.
Yeasts are fungi that grow as single cells, producing daughter cells either by budding (the budding yeasts) or by binary fission (the fission yeasts) They differ from most fungi, which grow as threadlike hyphae. Yeast cells are normal in the rectum and stool;. Yeast (Saccharomyces cerevisiae) is a fungus belongs to the phylum Ascomycota Yeast is an unicellular eukaryotic, heterotrophic organism without differentiated plant body It is a widely studied model organism for understanding the eukaryotic cell structure and function Sharing is Caring.
Cotransform yeast cells (which lack this transcription factor TF) if protein X and “prey” (from library) interact, the 2 domains of yeast TF will be close together (& functional), so activate reporter gene Fig 615 eg if use lacZ reporter gene – blue colour of yeast colony Topic 10 Proteomics Proteomics finding proteins that interact with protein of interest. Yeast cells released from a biofilm have novel properties, including increased virulence and drug tolerance Zap1 Zap1, also known as Csr1 and Sur1 (zincresponsive activator protein), is a transcription factor which is required for the hypha formation in C albicans biofilms Zap1 controls the. Bacteria, Fungi, Candida, Yeast cells, or Parasites There are no bacteria, parasites or yeast cells in urine normally If these are present, it can mean you have an infection If these are present, it can mean you have an infection.
Yeasts are considered model systems for eukaryotic studies as they exhibit fast growth and have dispersed cells Moreover, replica plating and mutant isolation of yeast cells can be done with relative ease and they have a welldefined genetic system Most significantly, yeasts have a highly versatile DNA transformation system that can be utilized effectively for protein production. When yeast is happy, a word the enthusiasts actually use in this context, its onecell body grows buds;. However, the singlechromosome and wildtype yeast cells have nearly identical transcriptome and similar phenome profiles The giant single chromosome can support cell life, although this strain shows reduced growth across environments, competitiveness, gamete production and viability.
Those buds grow so fast that they quickly break off, each becoming a new body And all the. When yeast is happy, a word the enthusiasts actually use in this context, its onecell body grows buds;. Used as a natural source of protein and omplex vitamins.
Staining is done to test whether yeast are viable or not (living or dead) A toxic staining agent, frequently methylene violet or methylene blue, is mixed with a yeast sample where it is quickly absorbed Living cells will force the staining agent out of the cell while the dead cells will not, and as such, will appear stained under a microscope 3. Yeast cells are nonmotile and are encased in a cell wall that supports high internal turgor pressure How do we know that yeast is a living organism?. Yeast is a living organism because it "burps" ,releasing carbon dioxide making it rise.
Yeast is a singlecelled fungus, which is alive and must make its own energy to survive The yeast in your bread uses a process called cellular respiration, where glucose is converted to ATP and. Two forms of yeast cells can survive and grow haploid and diploid The haploid cells undergo a simple lifecycle of mitosis and growth, and under conditions of high stress will, in general, die This is the asexual form of the fungus The diploid cells (the preferential 'form' of yeast) similarly undergo a simple lifecycle of mitosis and growth. Yeast are microscopic, singlecelled organisms that are classified in the family Fungi Individual yeast cells multiply rapidly by the process of budding, in which a new cell begins as a small bulge along the cell wall of a parent cell In the presence of an abundant food source, huge populations of yeast cells gather.

Yeast Cells Genetically Modified To Create Morphine Like Painkiller Drugs The Guardian

Yeast Cells Sem Framed Prints Wall Art Posters Jigsaws

Yeast Cells Computer Illustration Of Budding Yeast Cells Saccharomyces Cerevisiae Known As Baker S Or Brewer S Yeast This Fungus Consists Of Single Vegetative Cells The Larger Mother Cells Are Budding Off Smaller Daughter
Yeast Cells のギャラリー

Screening Yeast Display Libraries Against Magnetized Yeast Cell Targets Enables Efficient Isolation Of Membrane Protein Binders Acs Combinatorial Science X Mol

Bright Field Microscopy Image Of Yeast Cells Including Sand Particles Download Scientific Diagram

False Col Sem Of Yeast Cells Framed Prints Wall Art

Yeast Cells Cell Biology Quatr Us Study Guides

104 Yeast Cells High Res Illustrations Getty Images

Fission Yeast Cells As Seen Under A Microscope Okinawa Institute Of Science And Technology Graduate University Oist

What Is Yeast And What Can It Do

Yeast Cell Diagram Science Diagram Biology Ks3 Ks4 Illustration Twinkl

Yeast Cells Under The Microscope Characteristics Habitat Observation

656 Yeast Cell Photos Free Royalty Free Stock Photos From Dreamstime
Does The Fact That Yeast Cells Absorb Oxygen And Exhale Carbon Dioxide Mean That Like Fungi They Are Animals Not Vegetables Quora

Novel Protein Positioning Technique Improves Functionality Of Yeast Cells Eurekalert Science News

Yeast Cells Light Micrograph Stock Image C047 7315 Science Photo Library

Yeast Best Friend Of The Baker And Brewer Otago Daily Times Online News

Yeast Cells In Urine Samplescience Background Stock Photo Download Image Now Istock

How Big Is A Budding Yeast Cell

A A Dic Microscope Image Of Yeast Cells B Segmentation Results Download Scientific Diagram

Counting Yeast Cells For Brewing And Wine Industries Sigma Aldrich

1 Novel Stress Tolerant Mechanisms Of Yeast Cells And Their Applications For Breeding Of Industrial Yeast Laboratory Of Applied Stress Microbiology

Ijms Free Full Text How Do Yeast Cells Contend With Prions

Electrospray Patterning Of Yeast Cells For Applications In Alcoholic Fermentation Scientific Reports

Where Is The Yeast Cell Located Or Found By Jack Myers On Prezi Next

Automated Yeast Cell Counting With The Luna Fl

Yeast Cells Sem Stock Image B250 1514 Science Photo Library

Sem Images For Both Non Budding And Budding Yeast Cells Before And Download Scientific Diagram

Counting Yeast Cells Technical Note 2

Introduction To Yeast Media Sigma Aldrich

Introduction To Yeast Transformation Sigma Aldrich

Budding Yeast Cells Saccharomyces Cerevisiae Stock Vector Royalty Free

Saccharomyces Yeast Cells Nikon S Microscopyu

Yeast Cells Sem Stock Image C001 0059 Science Photo Library

Cellular Fractionation Yeast Cells Sciencedirect

A Protein That Extends Life Of Yeast Cells

Yeast Cell Vector Images Stock Photos Vectors Shutterstock

Solved 4 Draw A Representative Yeast Cell Include Magni Chegg Com

Yeast Analysis In Brewing Autocellcount

Science Source Stock Photos Video Yeast Cells Sem

Yeast Cells Handle Stress By Reprogramming Their Metabolism
Q Tbn And9gct6kb1cwrsafbdbcizstvixa3wgotytv0vomagbqjnclk2uamas Usqp Cau

Anaerobic Respiration By Yeast Cells Teaching Resources

Budding Yeast Cells Image Eurekalert Science News

More About Yeast And The Collection Phaff Yeast Culture Collection

Major Differences 6 Differences Between Plant Cell And Yeast Cell

Signaling In Yeast Biology For Majors I

Yeast Bubbles Experiments On Microscopes 4 Schools

656 Yeast Cell Photos Free Royalty Free Stock Photos From Dreamstime
Q Tbn And9gcqyrxk42datrngs8qllnjhyggcsbujn44zn1cp Cbryydrqfdx7 Usqp Cau

Frontiers Endoplasmic Reticulum Involvement In Yeast Cell Death Oncology

Yeast Wikipedia

How Dividing Cells Accurately Split Their Dna To Avoid Terrible Consequences U Of T Study

A Schematic Diagram Of Yeast Cell Download Scientific Diagram

Yeast Wikipedia

Aging Yeast Cells Undergo A Sharp Entry Into Senescence Unrelated To The Loss Of Mitochondrial Membrane Potential Sciencedirect

Stanford Engineers Reprogram Yeast Cells To Become Microscopic Drug Factories Mirage News

Continuous Ethanol Production Using Immobilized Yeast Cells Entrapped In Loofa Reinforced Alginate Carriers

Scientists Engineer Baker S Yeast To Produce Penicillin Molecules Imperial News Imperial College London

Genetically Engineer Yeast To Be Fluorescent Science Project

Fission Yeast Cell Cycle Pombenet Forsburg Lab Usc Dana And David Dornsife College Of Letters Arts And Sciences

Yeast Key To Understanding Cell Division

Budding Yeast Cells Stock Photo Download Image Now Istock

Budding Asexual Reproduction Of Yeast Cell Cross Section Of Royalty Free Cliparts Vectors And Stock Illustration Image

Sem Of Unidentified Yeast Cells Photograph By Microfield Scientific Ltd Science Photo Library

Top Tips For Yeast Microscopy

Yeast Wikipedia
Budding Yeast Cells Why They Matter And Why You Should Count Them

How Big Is A Budding Yeast Cell

Direct Yeast Cell Count At Od600 Tip Biosystems

Yeast Cells In Urine Specimens Stock Photo K Fotosearch

Budding Yeast Cells In Urine Stock Photo Picture And Royalty Free Image Image

57 Budding Of Yeast Cells Youtube

A Graph Of A Population Of Yeast Cells In A New Laboratory Culture As A Function Of Time From T 0 To T 18 Is Shown A Describe How The

Yeast E Coli Hybrid Shows How Mitochondria Might Have Evolved Science News

Basic Knowledge Of Yeast Definition Examples Diagrams

3 1 1 5 Yeast Cells Get My Grades

Morphology Of Yeast Cells Cells Were Grown In The Presence Or Absence Download Scientific Diagram

Budding Yeast Cells With Pseudohyphae Stock Photo

Reading Rise Of The Yeast Cells

Final Numbers Are In 42 Million Protein Molecules In A Yeast Cell

How Yeast Cells Detect Genetic Infections Eth Zurich

Yeast Cell An Overview Sciencedirect Topics

How To Synthesize A New Kind Of Yeast Cell Or Person Kurzweil

Growing Yeast Cells Clipart Etc

Yeast Cells Sem Stock Image B250 1095 Science Photo Library

Probing Yeast Cells To Understand Cell Misregulation Technology Networks
Q Tbn And9gcszqmgpagx Tqazi0slp93flmnpvnmsvm3 8gny9qj6islmic4h Usqp Cau

Yeast

Yeast Cells Microcosmos

Uandsh8u2sghvm
Budding Yeast Cells Why They Matter And Why You Should Count Them

Yeast Cells At Work News Events University Of Miami

Yeast Definition Uses Britannica

Figure 1 Molecular And Operational Definitions Of Yeast Cell Death
Fit A Model For The Growth Of Yeast Cells Biii

Budding Yeast Cells With Pseudohyphae Stock Photo Download Image Now Istock
Uw Team Programs Solitary Yeast Cells To Say Hello To One Another Uw News

Observing Yeast Under The Microscope Microscope Club

Yeast Cells Phagocytosis By White Blood Cell In Blood Smear Fungus Stock Photo Picture And Royalty Free Image Image

Yeast Cells In Urine Urinal Yeast Cell

Determination Of Vitality Of Yeast Cells Autocellcount

3 4 Use Of Immobilized Yeast Cells In Alcohol Fermentation S



